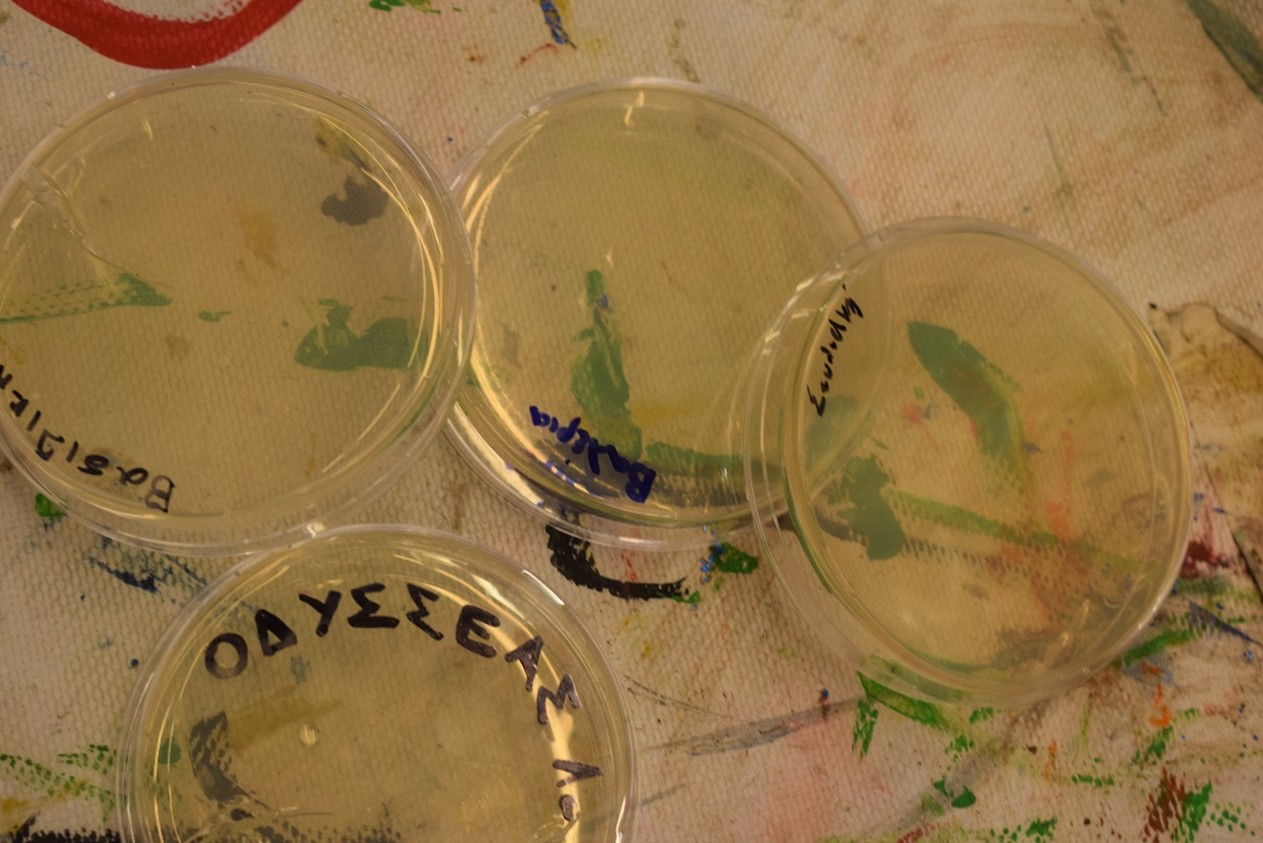
Εικόνα4

Εκεί φυτεύτηκε ο σπόρος αυτής της συνεργασίας πέρυσι με 2 εργαστήρια για παιδιά ηλικίας από 5-12 ετών. To 1o με τίτλο «Σκουπίδια και Παιχνίδια» έγινε με παιδιά ηλικίας 5 έως 8 ετών και αφορούσε την εξοικείωση των παιδιών με ένα zero waste τρόπο ζωής αλλά και έννοιες όπως η ανταλλαγή, η επαναχρησιμοποίηση και η κομποστοποίηση. Τα παιδιά είχαν τη δυνατότητα να φτιάξουν το δικό του κομπόστ και να το χρησιμοποιήσουν δημιουργώντας το δικό τους γλαστράκι!


Το 2ο εργαστήριο «Βιολογία και Θαύματα» πραγματοποιήθηκε σε κύκλο δύο εργαστηρίων και αφορούσε παιδιά από 8 έως 12 ετών. Σε αυτό τα παιδιά ήρθαν σε επαφή με τις έννοιες των μικροοργανισμών ενώ είχαν τη δυνατότητα να δουν τους μικροοργανισμούς που είναι παντού γύρω μας!
Στη συνέχεια πειραματιστήκαμε με τις έννοιες των κυττάρων και απομονώσαμε το δικό μας DNA!

Η συμμετοχή ήταν μεγάλη αλλά και η χαρά μας για την αλληλεπίδραση και τον ενθουσιασμό των παιδιών μεγαλύτερη... Και για το λόγο αυτό η συνεργασία συνεχίζεται και φέτος!
Το πρώτο εργαστήριο για την φετινή χρονιά πραγματοποιήθηκε την Κυριακή 12 Νοεμβρίου αλλά κάθε μήνα θα ανανεώνουμε το ραντεβού μας κάποια Κυριακή στο Μουσείο Ηρακλειδών!!
Save the dates λοιπόν:
- Κυριακή 10/12/2023 ΒΙΟΛΟΓΙΑ
- Κυριακή 7/1/2024 ΒΙΟΧΗΜΕΙΑ
- Κυριακή 4/2/2024 ΒΙΟΧΗΜΕΙΑ
- Κυριακή 10/3/2024 ΧΗΜΕΙΑ
- Κυριακή 7/4/2024 ΧΗΜΕΙΑ
Λεπτομέρειες για το κάθε εργαστήριο αλλά και για την αγορά των εισιτηρίων θα βρίσκεται στον παρακάτω σύνδεσμο https://www.herakleidon.org/activities/sciense
Σχεδιασμός, υλοποίηση: Χατζηδάκη Μαρία, Πανδώρα Καρακούση
Υποστήριξη, παρουσίαση: Πένυ Αρτεμάκη, Αφροδίτη Μουλαρά, Μελίνα Λένη, Υακίνθη Μπατσή
Φωτογραφίες: Εύα Βασιλειάδη
